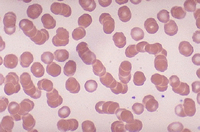
bloodcells2.jpg

NaturalNews) Inside chlorophyll is the lamp of life and that lamp is magnesium. The capture of light energy from the sun is magnesium dependent. Magnesium is bound as the central atom of the porphyrin ring of the green plant pigment chlorophyll. Magnesium is the element that causes plants to be able to convert light into energy and chlorophyll is identical to hemoglobin except the magnesium atom at the center has been taken out and iron put in. The whole basis of life and the food chain is seen in the sunlight-chlorophyll-magnesium chain. Since animals and humans obtain their food supply by eating plants, magnesium can be said to be the source of life for it is at the heart of chlorophyll and the process of photosynthesis.
A huge step forward for early life was the development of chlorophyll, a molecule that captures light energy from the sun in a process called photosynthesis. Chlorophyll systems convert energy from visible light into small energy-rich molecules easy for cells to use. The harnessing of the energy of visible light led to a vast expansion of early life-forms. Fossilized layers, three and half billion years old, have been found with evidence of blue-green algae that lived on top of tidal rocks.
Magnesium is needed by plants to form chlorophyll which is the substance that makes plants green. Without magnesium sitting inside the heart of chlorophyll, plants would not be able to take nutrition from the sun because the process of photosynthesis would not go on. When
magnesium is deficient things begin to die. In reality one cannot take a breath, move a muscle, or think a thought without enough magnesium in our cells. Because magnesium is contained in chlorophyll it is considered an essential plant mineral salt.
Without chlorophyll, plants are unable
to convert sunlight and carbon dioxide.
There is no
life without magnesium.
Magnesium is a necessary element for all living organisms both animal and plant. Chlorophyll is structured around a magnesium atom, while in animals, magnesium is a key component of cells, bones, tissues and just about every physiological process you can think of. Magnesium is primarily an intracellular cation; roughly 1% of whole-body magnesium is found extracellularly, and the free intracellular fraction is the portion regulating enzyme pathways inside the cells. Life packs the magnesium jealously into the cells, every drop of it is precious.
Insulin and Magnesium
Magnesium is necessary for both the action
of
insulin and the manufacture of insulin.
Magnesium is a basic building block to life and is present in ionic form throughout the full landscape of human physiology. Without insulin though, magnesium doesn't get transported from our blood into our cells where it is most needed. When Dr. Jerry Nadler of the Gonda Diabetes Center at the City of Hope Medical Center in Duarte, California, and his colleagues placed 16 healthy people on magnesium-deficient diets, their insulin became less effective at getting sugar from their blood into their cells, where it's burned or stored as fuel. In other words, they became less insulin sensitive or what is called insulin resistant. And that's the first step on the road to both diabetes and heart disease.
Insulin is a common denominator, a central figure in life as is magnesium. The task of insulin is to store excess nutritional resources.
This system is an evolutionary development used to save energy and other nutritional necessities in times (or hours) of abundance in order to survive in times of hunger. Little do we appreciate that insulin is not just responsible for regulating sugar entry into the cells but also magnesium, one of the most important substances for life. It is interesting to note here that the kidneys are working at the opposite end physiologically dumping from the blood excess nutrients that the body does not need or cannot process in the moment.
Controlling the level of blood sugars is only one of the many functions of insulin. Insulin plays a central role in storing magnesium but if our cells become resistant to insulin, or if we do not produce enough insulin, then we have a difficult time storing magnesium in the cells where it belongs. When insulin processing becomes problematic magnesium gets excreted through our urine instead and this is the basis of what is called magnesium wasting disease.
There is a strong relationship between magnesium and insulin action. Magnesium is important for the effectiveness of insulin. A reduction
of magnesium in the cells strengthens insulin resistance.
Low serum and intracellular magnesium concentrations are associated with insulin resistance, impaired glucose tolerance, and decreased insulin secretion. Magnesium improves insulin sensitivity thus lowering insulin resistance. Magnesium and insulin need each other. Without magnesium, our pancreas won't secrete enough insulin--or the insulin it secretes won't be efficient enough--to control our blood sugar.
Magnesium in our cells helps the muscles to relax but if we can't store magnesium because the cells are resistant then we lose magnesium which makes the blood vessels constrict, affects our energy levels, and causes an increase in blood pressure. We begin to understand the intimate connection between diabetes and heart disease when we look at the closed loop between declining magnesium levels and declining insulin efficiency.
Though it would be a long stretch of the longest giraffe's neck to compare insulin with chlorophyll we are walking a trail at the very nuclear core of life. It's the magnesium trail and we find to our surprise that it takes us into intimate contact with the very structure and foundation of life. The dedication of this chapter is to the beauty of magnesium, to its meaning in life, in health and in
medicine.
We were talking about chlorophyll and now insulin and putting magnesium in-between. Walking further along is the DHEA magnesium story and the DNA magnesium story. And then there is the cholesterol magnesium story. Every part of life is in love with magnesium except allopathic medicine which just cannot accept it in all its light, flame and beauty. Thousands of years ago the Chinese named it the beautiful metal and they were seeing something pharmaceutical medicine does not want to see for there is little money to be made from something so common.
Magnesium and DNA
Magnesium ions play critical roles in many aspects of cellular metabolism. Magnesium stabilizes structures of proteins, nucleic acids, and cell membranes by binding to the macromolecule's surface and promote specific structural or catalytic activities of proteins, enzymes, or ribozymes. Magnesium has a critical role in cell division. It has been suggested that magnesium is necessary for the maintenance of an adequate supply of nucleotides for the synthesis of RNA and DNA.
Magnesium plays a critical role in vital DNA repair proteins.
Magnesium ions synergetic effects on the active site
geometry may affect the polymerase closing/opening trends.
Single-stranded RNA are stabilized by magnesium ions.
Distinct structural features of DNA, such as the curvature of dA tracts, are important in the recognition, packaging, and regulation of DNA are magnesium dependent. Physiologically relevant concentrations of magnesium have been found to enhance the curvature of dA tract DNAs. The chemistry of water activated by a magnesium ion is central to the function of the DNA repair proteins, apurinic/apyrimidic endonuclease 1 (Ape1) and polymerase A (Pol A). These proteins are key constituents of the base excision repair (BER) pathway, a process that plays a critical role in preventing the cytotoxic and mutagenic effects of most spontaneous, alkylation, and oxidative DNA damage.
Magnesium ions help guide polymerase selection for the
correct nucleotide extends descriptions of polymerase pathways.
Dr. Paul Ellis informs us that, "Magnesium ions are central to the function of the DNA repair proteins, apurinic/apyrimidic endonuclease 1 (Ape1) and polymerase A (Pol A). These proteins are key constituents of the base excision repair (BER) pathway, a process that plays a critical role in preventing the cytotoxic and mutagenic effects of most spontaneous, alkylation, and oxidative DNA damage." DNA polymerase is considered to be a holoenzyme since it requires a magnesium ion as a co-factor to function properly. DNA-Polymerase initiates DNA replication by binding to a piece of single-stranded DNA. This process corrects mistakes in newly-synthesized DNA.
DHEA – Magnesium - Cholesterol
Low levels of DHEA are associated with loss of "pathology
preventing" signaling between immune system cells.
Dr. James Michael Howard says, "Cancer and infections are both increasing and one of the basic reasons is reduced availability of DHEA, which stems from magnesium deficiency." Also known as "mother of all steroid hormones" DHEA is converted in the body into several different hormones, including estrogen and testosterone. DHEA appears to restore immune balance and stimulate monocyte production (the cells that attack tumors), B-cell activity (the cells that fight disease-causing organisms), T-cell mobilization (infection fighting T-cells have DHEA binding sites), and protection of the thymus gland (which produces T-cells). The data suggest that DHEA has a role in the neuro-endocrine regulation of the antibacterial immune resistance.
All steroid hormones are created from cholesterol in a hormonal cascade. Cholesterol, that most maligned compound, is actually crucial for health and is the mother of hormones from the adrenal cortex, including cortisone, hydrocortisone, aldosterone, and DHEA. Cholesterol cannot be synthesized without magnesium and cholesterol is a vital component of many hormones. These hormones are interrelated, each performing a unique biological function with them all depending on magnesium for their function. Aldosterone interestingly needs magnesium to be produced and it also regulates magnesium's balance.
Dr. Mildred S. Seelig wrote, "Mg2+-ATP is the controlling factor for the rate-limiting enzyme in the cholesterol biosynthesis sequence that is targeted by the statin pharmaceutical drugs, comparison of the effects of Mg2+ on lipoproteins with those of the statin drugs is warranted. Formation of cholesterol in blood, as well as of cholesterol required in hormone synthesis, and membrane maintenance, is achieved in a series of enzymatic reactions that convert HMG-CoA to cholesterol. The rate-limiting reaction of this pathway is the enzymatic conversion of HMG CoA to mevalonate via HMG CoA. The statins and Mg inhibit that enzyme. Mg has effects that parallel those of statins. For example, the enzyme that deactivates HMG-CoA Reductase requires Mg, making Mg a Reductase controller rather than inhibitor. Mg is also necessary for the activity of lecithin cholesterol acyl transferase (LCAT), which lowers LDL-C and triglyceride levels and raises HDL-C levels."
Desaturase is another Mg-dependent enzyme involved in
lipid metabolism which statins do not directly affect.
DHEA is a steroid hormone produced by the adrenal gland and ovaries and converted to testosterone and estrogen. After being secreted by the adrenal glands, it circulates in the bloodstream as DHEA-sulfate (DHEAS) and is converted as needed into other hormones. Magnesium chloride, when applied transdermally, is reported by Dr. Norman Shealy to increase DHEA. Dr. Shealy has determined that when the body is presented with adequate levels of magnesium at the cellular level, the body will begin to naturally produce DHEA and also DHEA-S.
Transdermal is the ultimate way to replenish cellular magnesium
levels. Every cell in the body bathes and feeds in it and even DHEA
levels are increased naturally, according to Dr. Norman Shealy
This effect is not seen in oral or intravenous magnesium administration and Dr. Shealy has a patent pending in this area. It is thought that transdermal application interacts in some way with the fatty tissues of the skin to create the affect. Studies link low levels of DHEA to chronic inflammation, immune dysfunction, depression, rheumatoid arthritis, Type-II diabetic complications, greater risk for certain cancers, heart disease and osteoporosis.
Magnesium and Glutathione
Without sufficient magnesium, the body accumulates toxins
and acid residues, degenerates rapidly, and ages prematurely.
According to Dr. Russell Blaylock, low magnesium is associated with dramatic increases in free radical generation as well as glutathione depletion and this is vital since glutathione is one of the few antioxidant molecules known to neutralize mercury. Glutathione requires magnesium for its synthesis. Glutathione synthetase requires γ-glutamyl cysteine, glycine, ATP, and magnesium ions to form glutathione.
In magnesium deficiency, the enzyme y-glutamyl transpeptidase is lowered. Data demonstrates a direct action of glutathione both in vivo and in vitro to enhance intracellular magnesium and a clinical linkage between cellular magnesium, GSH/GSSG ratios, and tissue glucose metabolism. Magnesium deficiency causes glutathione loss, which is not affordable because glutathione helps to defend the body against damage from cigarette smoking, exposure to radiation, cancer chemotherapy, and toxins such as alcohol and just about everything else.
Scientific Miracles in Medicine
The 21st century is seeing the plagues of diabetes, heart disease, cancer and neurological diseases explode with the entire western medical establishment confused about even the most basic health issues. The three trillion dollar medical machine in the United States is impotent against chronic diseases and is responsible itself for much of the horror that is happening.
Medical basics, we have to get back to them returning to the understanding of the simplest things like water. What do you give a person coming out of a week long walk in the desert without water? A coke? Do we have to do a thousand double blind studies to realize there is only one answer? Are we that dumb that medicine cannot see the forest from the trees?
When someone is in cardiac arrest or are having a stroke, having panic attacks with heart palpitations what is the first thing, the very first thing we would reach for like one would reach for a six shooter? Our biological engine is seizing up what do we do? For the next million years there is going to be only one answer and that answer is magnesium preferably in the chloride form. It will never change either for that person coming out of the desert; water will always be the answer to the need. We are talking so close to the source of life when talking about water or magnesium. But unfortunately there will always be those who think giving a coke to a very thirsty person is just fine and doctors who think they can forget about nature and try to substitute something to stand in magnesium's place.
The bedrock of medical truth sits upon the metal magnesium for it is at the exact center of biological life like air and water is. All of life collapses around its loss, but with only the smallest amount of caring and intelligence we can replete what has been lost inside of a person's cells. The realization that magnesium is at the center of life in chlorophyll should help us place magnesium in the temple it deserves. It is the ultimate love drug when used as a medicine. It's the first thing you give a person if you want to give something necessary and helpful.
It will take this entire book to present all the reasons that magnesium qualifies as a love drug; there are reasons that take us out of the physical body and into emotional, mental and spiritual bodies. Psychologists and psychiatrists also have to discover magnesium for it offers them a tool they have not found anywhere else. Magnesium is the Lamp of Life; it operates at the core of physiology offering us what can only be called scientific miracles in medicine. Though other substances like Vitamin C or even iodine are powerful competitors they cannot compare in sheer healing horsepower to magnesium.
.
Magnesium Medicine
It is no exaggeration for me to say that magnesium saved my life.
But is ironic that I am the one saying it, because during my
diverse medical career in general medicine, my greatest expertise
has always been prescription drugs, not natural supplements.
Dr. Jay S. Cohen
The Magnesium Solution for High Blood Pressure
Magnesium serves hundreds of important functions in the body and for that reason it has virtually no side effects. Researchers all over the world have confirmed its vital role yet, despite the intensive scientific brainpower that has been directed toward magnesium most doctors know hardly anything about it and never consider magnesium for treating patients. Magnesium comes to us with scientific evidence that dwarfs the evidence presented by pharmaceutical companies for any of their prescription drugs but its use is still contained. (See chapter on why doctors do not use more magnesium)
Magnesium chloride treatments address systemic nutritional deficiencies, act to improve the function of our cells and immune system, and help protect cells from oxidative damage. Its a systemic medicine as well as a local one bringing new life and energy to the cells wherever it is applied topically. When used with oral administration, transdermal magnesium therapy offers us the opportunity to get dosages up to the powerful therapeutic range without compromising intestinal comfort through oral use alone.
What we have found is that magnesium chloride, applied
transdermally, is the ideal magnesium delivery system -
with health benefits unequalled in the entire world of medicine.
Magnesium chloride solutions offer a medical miracle to humanity, one that many have sought but have not found. In fact Dr. Carolyn Dean, titled her book The Magnesium Miracle and she could not have been more correct. Nothing short of a miracle is to be expected with increases in the cellular levels of magnesium if those levels have been depleted.
There is no wonder drug that can claim, in the clear, what magnesium chloride can do. Most people will show dramatic improvements in the state of their health when they replete their magnesium levels and the very best way to do that is with magnesium chloride applied transdermally (baths and body spraying), orally, vaporized into the lungs, diluted for use with ones eyes, intravenously, and even in douches and enemas.
Constant magnesium massages are what kings and queens should be dreaming of.
With such "brine solutions" the concentrate can simply be applied to the skin or poured into bath water, and in an instant we have a medical treatment without equal in the world of medicine. Intensive transdermal and oral magnesium therapy can be safely applied every day for constantly strengthened health.
Hidden in each cubic mile of ocean water is enough healing
power to put the pharmaceutical companies out of business.
And there are medical reasons why we love the beach and ocean. Intensive magnesium baths, aerosolized iodine, vitamin D natural style and grounding to the earth through the sand. Medical science and the pharmaceutical companies will eventually have to deal with the fact that the most powerful and universal medicine on earth is a basic nutrient from the sea and can be purchased by anyone at low cost.
Magnesium is nothing short of a miracle to a person deficient in this mineral. So clear and observable are the effects that there is no mistake, no mysticism, no false claim made.
Emergency room personnel know of this and use either magnesium sulfate or chloride to save peoples lives during heart attacks or to diminish the damage from strokes. And new research suggests that MgSO4 infusions may have a role in cerebral vasospasm prophylaxis if therapy is initiated within 48 hours of aneurysm rupture.
Medicine today is more and more frequently described in terms of science. With the origin and development of drugs and surgical techniques, modern medicine has thought itself to be evermore exact and evermore resembling the hard sciences of chemistry and physics. In the case of magnesium, medicine has fallen from the grace of the pure sciences, which insists that they are ignoring the best medicine available anywhere. Magnesium is clearly evidence-based medicine but the quality of the evidence used pharmaceutical medicine is highly suspect. There is no such cloud of doubt hanging over the scientific evidence that makes it clear why magnesium would be both potent and safe.
When it comes to cardiac disease we create our primary protocol around magnesium, selenium and iodine. These three core minerals, when backed up with a strong naturopathic protocol, which includes natural mercury detoxification of the heart tissues, will transform cardiology into a field of medicine that does not have its patients dying like flies.
About the author
Mark A. Sircus Ac., OMD, is director of the International Medical Veritas Association (IMVA)
Dr. Sircus | International Medical Veritas Association. Dr. Sircus was trained in acupuncture and oriental medicine at the Institute of Traditional Medicine in Sante Fe, N.M., and in the School of Traditional Medicine of New England in Boston. He served at the Central Public Hospital of Pochutla, in México, and was awarded the title of doctor of oriental medicine for his work. He was one of the first nationally certified acupuncturists in the United States. Dr. Sircus's IMVA is dedicated to unifying the various disciplines in medicine with the goal of creating a new dawn in healthcare.
He is particularly concerned about the effect vaccinations have on vulnerable infants and is identifying the common thread of many toxic agents that are dramatically threatening present and future generations of children. His book The Terror of Pediatric Medicine is a free e-book one can read. Dr. Sircus is a most prolific and courageous writer and one can read through hundreds of pages on his various web sites.
He has most recently released his Survival Medicine for the 21st Century compendium (2,200 page ebook) and just released the Winning the War Against Cancer book. Dr. Sircus is a pioneer in the area of natural detoxification and chelation of toxic chemicals and heavy metals. He is also a champion of the medicinal value of minerals and is fathering in a new medical approach that uses sea water and different concentrates taken from it for health and healing. Transdermal Magnesium Therapy, his first published work, offers a stunning breakthrough in medicine, an entirely new way to supplement magnesium that naturally increases DHEA levels, brings cellular magnesium levels up quickly, relieves pain, brings down blood pressure and pushes cell physiology in a positive direction. Magnesium chloride delivered transdermally brings a quick release from a broad range of conditions.
International Medical Veritas Association:
Dr. Sircus | International Medical Veritas Association
Learn more:
Magnesium: The Lamp of Life The pH in the human digestive tract varies greatly (see Human Digestive Tract pH Range Chart on the left side). The pH of saliva is usually between 6.5 - 7.5. After we chew and swallow food it then enters the fundic or upper portion of the stomach which has a pH between 4.0 - 6.5. This is where "predigestion" occurs while the lower portion of the stomach is secreting hydrochloric acid (HCI) and pepsin until it reaches a pH between 1.5 - 4.0. After the food mixes with these juices it then enters the duodenum (small intestine) where the pH changes to 7.0 - 8.5. This is where 90% of the absorption of nutrients is taken in by the body while the waste products are passed out through the colon (pH 4.0 - 7.0).
The pH in the human digestive tract varies greatly (see Human Digestive Tract pH Range Chart on the left side). The pH of saliva is usually between 6.5 - 7.5. After we chew and swallow food it then enters the fundic or upper portion of the stomach which has a pH between 4.0 - 6.5. This is where "predigestion" occurs while the lower portion of the stomach is secreting hydrochloric acid (HCI) and pepsin until it reaches a pH between 1.5 - 4.0. After the food mixes with these juices it then enters the duodenum (small intestine) where the pH changes to 7.0 - 8.5. This is where 90% of the absorption of nutrients is taken in by the body while the waste products are passed out through the colon (pH 4.0 - 7.0). 
 Shown here are four representations chemists use for molecular oxygen. In colored molecular models, oxygen is traditionally shown in red.
Shown here are four representations chemists use for molecular oxygen. In colored molecular models, oxygen is traditionally shown in red.